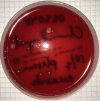
Figure 2

Periodontitis increases risk of viable bacteria in freshly drawn blood donations
- PMID: 33539285
- PMCID: PMC8486607
- DOI: 10.2450/2021.0336-20
Periodontitis increases risk of viable bacteria in freshly drawn blood donations
Abstract
Background: The aim of the study was to determine if periodontitis, which often causes transient bacteraemia, associates with viable bacteria in standard blood donations.
Materials and methods: This was a cross-sectional study of 60 self-reported medically healthy blood donors aged over 50 years. According to standard procedures, whole blood was separated by fractionation into plasma, buffy-coat, and red blood cell (RBC)-fractions. The buffy-coat was screened for bacterial contamination using BacT/ALERT. Samples from plasma and RBC-fractions were incubated anaerobically and aerobically at 37°C for 7 days on trypticase soy blood agar (TSA). For identification, colony polymerase chain reaction was performed using primers targeting 16S rDNA.
Results: From 62% of the donors with periodontitis, bacterial growth was observed on at least 1 out of 4 plates inoculated with plasma or RBCs, whereas only 13% of plates inoculated with plasma or RBCs from periodontally healthy controls yielded bacterial growth (relative risk 6.4, 95% CI: 2.1; 19.5; p=0.0011). None of the donors tested positive for bacterial contamination using BacT/ALERT. Cutibacterium acnes was found in 31% of the donations from donors with periodontitis and in 10% of the donations from periodontally healthy donors. In addition, Staphylococcus species, Bacillus mycoides, Aggregatibacter aphrophilus, and Corynebacterium kroppenstedtii were detected.
Discussion: Periodontitis increased the risk of bacterial contamination of blood products. Contaminating bacteria are often associated with the RBC-fraction. As the BacT/ALERT test is generally performed on platelet products, routine screening fails to detect many occurrences of viable bacteria in the RBC-fraction.
Conflict of interest statement
The Authors declare no conflicts of interest.
Figures

References
-
- Chassé M, McIntyre L, English SW, et al. Effect of blood donor characteristics on transfusion outcomes: a systematic review and meta-analysis. Transf Med Rev. 2016;30:69–80. - PubMed
-
- WHO. Blood safety and availability. WHO Glob Database Blood Saf. 2014. [Accessed on 23/09/2020]. Available at: http://www.who.int/mediacentre/factsheets/fs279/en.
-
- Kuehnert MJ, Roth VR, Haley NR, et al. Transfusion-transmitted bacterial infection in the United States, 1998 through 2000. Transfusion. 2000;41:1493–9. - PubMed
Publication types
MeSH terms
LinkOut - more resources
Full Text Sources
Medical
Research Materials
